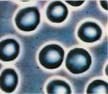

Live Blood Analysis is a screening test for hematological status using darkfield, Phase Contrast, and brightfield microscopy. By observing various conditions in a sample of blood, health professionals are able to customize a nutritional program specifically geared for the individual needs of the patient. Using the microscope in this way to evaluate shapes and other properties of individual blood cells, properly trained professionals have been able to observe some startling nutritional disorders. These disorders include some conditions that cannot easily be found by using the traditional method of blood analysis.
It should be noted that blood analysis by microscopy is not a diagnostic procedure and should not be used as such. This method was designed as a screening test to help take the guesswork out of selecting the appropriate nutritional program for the individual patient. The advantage of the blood microscopy analysis is that many nutritional disorders can be detected before standard blood tests can detect any chemical changes. Generally then, treatment can be more successful because these problems are discovered when they are still in their infant stages. This would be considered as true preventative nutrition.
| Erythrocyte aggregation | |
| before | after |
![]() | ![]() |
| Free radical damage | |
| before | after |
![]() | ![]() |
| Crystals | |
| before | after |
![]() | ![]() |